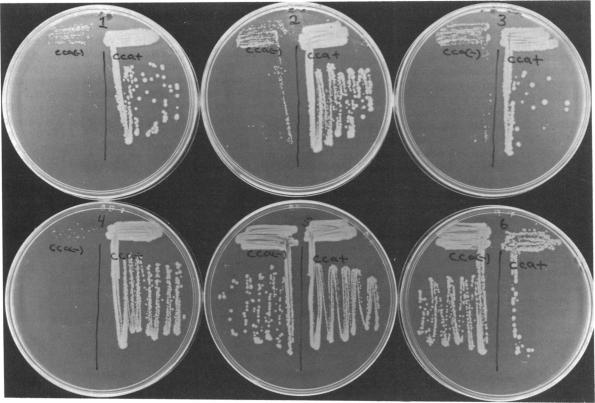
https://cdn.ncbi.nlm.nih.gov/pmc/blobs/ba06/390729/d0985f032a77/pnas00359-0070-a.jpg

核糖核酸酶T负责大肠杆菌中转运RNA的末端周转。
RNase T is responsible for the end-turnover of tRNA in Escherichia coli.
作者信息
Deutscher M P, Marlor C W, Zaniewski R
出版信息
Proc Natl Acad Sci U S A. 1985 Oct;82(19):6427-30. doi: 10.1073/pnas.82.19.6427.
A mutant strain deficient in RNase T was isolated and used to study the role of this enzyme in Escherichia coli. Strains lacking as much as 70% of RNase T activity, alone or in combination with the absence of other RNases, display normal growth properties. However, in cca strains, which lack tRNA nucleotidyltransferase, RNase T-deficient derivatives accumulate lower levels of defective tRNA and grow at increased rates compared to their RNase T+ parents. Slow-growing cca strains revert to a faster-growing form that contains less defective tRNA but which is still cca. All of these strains have decreased levels of RNase T. These data indicate that RNase T is responsible for nucleotide removal during the tRNA end-turnover process and that the amount of defective tRNA in cells is determined by the relative levels of RNase T and tRNA nucleotidyltransferase.
分离出一种缺乏核糖核酸酶T的突变菌株,并用于研究该酶在大肠杆菌中的作用。单独或与其他核糖核酸酶缺失相结合,缺乏高达70%核糖核酸酶T活性的菌株表现出正常的生长特性。然而,在缺乏tRNA核苷酸转移酶的cca菌株中,与它们的核糖核酸酶T+亲本相比,核糖核酸酶T缺陷衍生物积累的缺陷tRNA水平较低,生长速度加快。生长缓慢的cca菌株回复为生长较快的形式,其含有较少的缺陷tRNA,但仍然是cca。所有这些菌株的核糖核酸酶T水平都降低了。这些数据表明,核糖核酸酶T负责tRNA末端周转过程中的核苷酸去除,并且细胞中缺陷tRNA的量由核糖核酸酶T和tRNA核苷酸转移酶的相对水平决定。